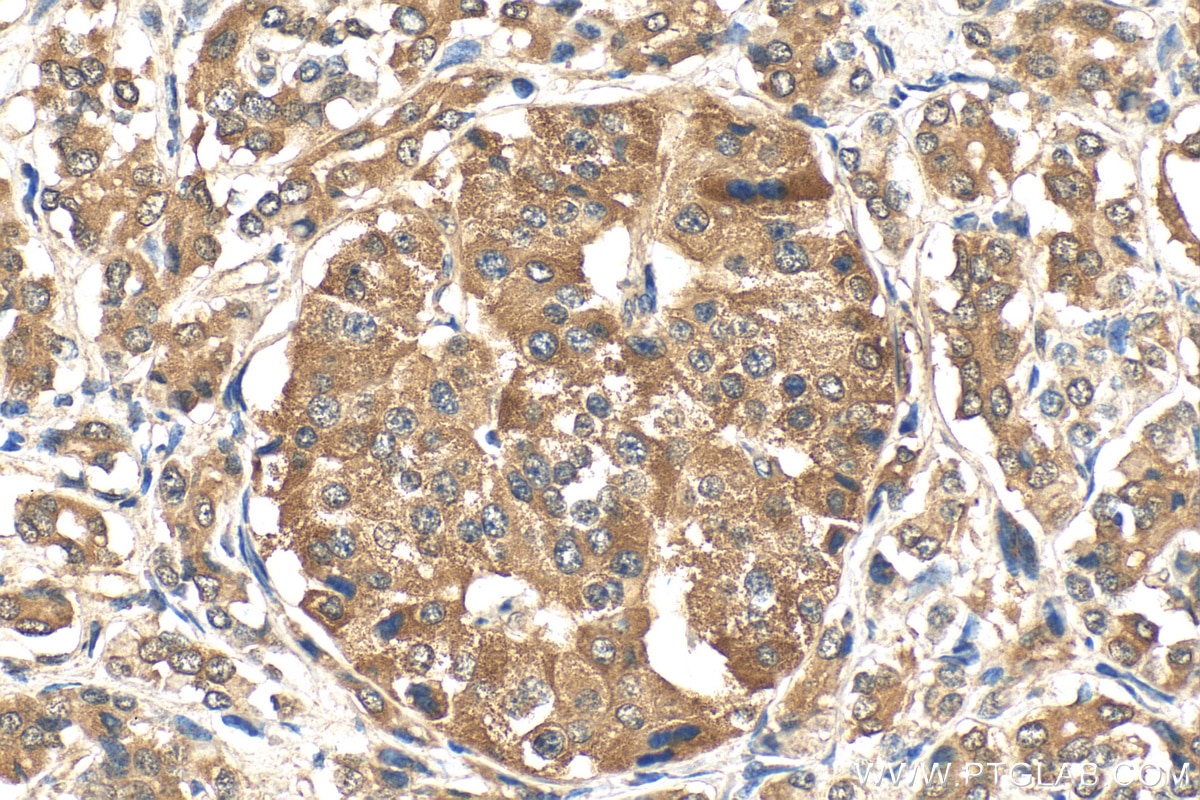

Validation Data Gallery
Tested Applications
| Positive WB detected in | HepG2 cells, A549 cells, HeLa cells |
| Positive IHC detected in | human pancreas cancer tissue, human breast cancer tissue, human colon cancer tissue, human kidney tissue, human liver cancer tissue, human renal cell carcinoma tissue Note: suggested antigen retrieval with TE buffer pH 9.0; (*) Alternatively, antigen retrieval may be performed with citrate buffer pH 6.0 |
| Positive IF/ICC detected in | MG132 treated HepG2 cells |
This antibody is only recommended for WB detection of human samples
Recommended dilution
| Application | Dilution |
|---|---|
| Western Blot (WB) | WB : 1:2000-1:12000 |
| Immunohistochemistry (IHC) | IHC : 1:50-1:500 |
| Immunofluorescence (IF)/ICC | IF/ICC : 1:50-1:500 |
| It is recommended that this reagent should be titrated in each testing system to obtain optimal results. | |
| Sample-dependent, Check data in validation data gallery. | |
Product Information
16396-1-AP targets NRF2, NFE2L2 in WB, IHC, IF/ICC, IP, CoIP, chIP, RIP, ELISA applications and shows reactivity with human samples.
| Tested Reactivity | human |
| Cited Reactivity | human, monkey, chicken, sheep, goat, yellow catfish, seiurus aurocapilla, ducks |
| Host / Isotype | Rabbit / IgG |
| Class | Polyclonal |
| Type | Antibody |
| Immunogen |
CatNo: Ag9489 Product name: Recombinant human NRF2, NFE2L2 protein Source: e coli.-derived, PGEX-4T Tag: GST Domain: 256-605 aa of BC011558 Sequence: SILSTEDPNQLTVNSLNSDATVNTDFGDEFYSAFIAEPSISNSMPSPATLSHSLSELLNGPIDVSDLSLCKAFNQNHPESTAEFNDSDSGISLNTSPSVASPEHSVESSSYGDTLLGLSDSEVEELDSAPGSVKQNGPKTPVHSSGDMVQPLSPSQGQSTHVHDAQCENTPEKELPVSPGHRKTPFTKDKHSSRLEAHLTRDELRAKALHIPFPVEKIINLPVVDFNEMMSKEQFNEAQLALIRDIRRRGKNKVAAQNCRKRKLENIVELEQDLDHLKDEKEKLLKEKGENDKSLHLLKKQLSTLYLEVFSMLRDEDGKPYSPSEYSLQQTRDGNVFLVPKSKKPDVKKN 相同性解析による交差性が予測される生物種 |
| Full Name | nuclear factor (erythroid-derived 2)-like 2 |
| Calculated molecular weight | 605 aa, 68 kDa |
| Observed molecular weight | 110 kDa, 68 kDa |
| GenBank accession number | BC011558 |
| Gene Symbol | NRF2 |
| Gene ID (NCBI) | 4780 |
| RRID | AB_2782956 |
| Conjugate | Unconjugated |
| Form | |
| Form | Liquid |
| Purification Method | Antigen affinity purification |
| UNIPROT ID | Q16236 |
| Storage Buffer | PBS with 0.02% sodium azide and 50% glycerol{{ptg:BufferTemp}}7.3 |
| Storage Conditions | Store at -20°C. Stable for one year after shipment. Aliquoting is unnecessary for -20oC storage. |
Background Information
NRF2, also named as NFE2L2, belongs to the bZIP family and CNC subfamily. It is a transcription activator that binds to antioxidant response (ARE) elements in the promoter regions of target genes. NRF2 is important for the coordinated up-regulation of genes in response to oxidative stress. It may be involved in the transcriptional activation of genes of the beta-globin cluster by mediating enhancer activity of hypersensitive site 2 of the beta-globin locus control region. Nrf2 is a key player in the regulation of genes encoding for many antioxidative response enzymes.The expression of NRF2 may be induced under oxidative stress (PMID:14567983).In lung cancer, Nrf2 activation in malignant cells has been associated with tumor progression and chemotherapy resistance(PMID:20534738). Identifying patients with abnormal NRF2 expression may be important for selection for chemotherapy in NSCLC. As new investigators break into the emerging field of Nrf2 research, confusion regarding the correct migratory pattern of Nrf2 is causing doubts about the accuracy and reproducibility of published results. This letter provides solid evidence that the actually observed molecular weight of Nrf2 is about 70kDa and 95-110 kDa. (PMID: 22703241).
Protocols
| Product Specific Protocols | |
|---|---|
| IF protocol for NRF2, NFE2L2 antibody 16396-1-AP | Download protocol |
| IHC protocol for NRF2, NFE2L2 antibody 16396-1-AP | Download protocol |
| IP protocol for NRF2, NFE2L2 antibody 16396-1-AP | Download protocol |
| WB protocol for NRF2, NFE2L2 antibody 16396-1-AP | Download protocol |
| Standard Protocols | |
|---|---|
| Click here to view our Standard Protocols |
Publications
| Species | Application | Title |
|---|---|---|
Gastroenterology Nucleolar HEATR1 upregulated by mTORC1 signaling promotes hepatocellular carcinoma growth by dominating ribosome biogenesis and proteome homeostasis | ||
Cancer Cell iASPP Is an Antioxidative Factor and Drives Cancer Growth and Drug Resistance by Competing with Nrf2 for Keap1 Binding.
| ||
Cell Metab Transsulfuration Activity Can Support Cell Growth upon Extracellular Cysteine Limitation. | ||